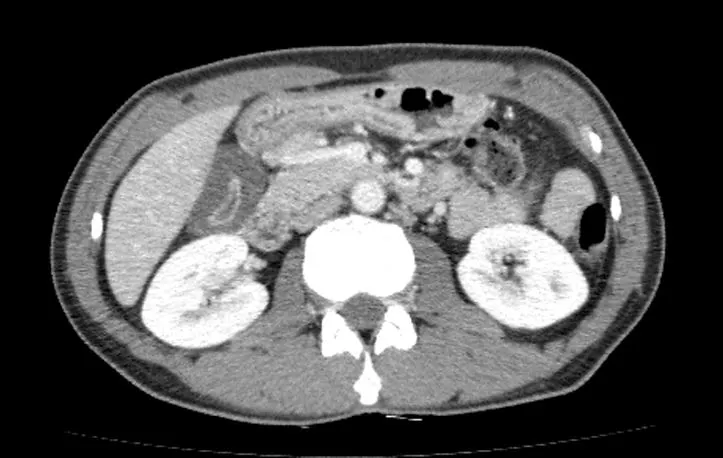

하수오를 아시나요?
-백하수오의 부작용에 대해서-
by
Sep 18. 2020
하수오(何首烏)는 중국이 원산지인 여러해살이 덩굴식물이다. 뿌리는 옆으로 길게 뻗으며 둥근 덩이뿌리가 생긴다. 심장형인 잎은 어긋나며 잎자루가 있고, 잎 가장자리에는 톱니가 없다. 꽃은 8 ~ 9월에 가지 끝에서 흰색으로 무리지어 원추꽃차례를 이루며, 열매는 세모진 달걀 모양이다. 하수오의 효능은 종기, 불면증 등 간과 신장을 보하고 머리를 검게한다. 덩이뿌리는 감기, 관절염, 신경쇠약 따위에 약으로 쓴다.[1] 의학서인 동의보감에 따르면, 중국 하씨(何氏) 성을 가진 사람이 하수오를 먹고 머리카락이 검어지면서 건강해졌다고 하여 하수오(何首烏)라고 전해진다.[2][3] 하수오에는 적하수오와 백하수오가 있는 데,중국 및 한국의 문헌에서 일반적으로 하수오라 고 지칭하는 것은 적하수오(Polygonum multiflorum) 를 말한다. 백하수오란 박주가 리과(Asclepiadaceae)의 큰조롱(Cynanchum wilfordii), 이엽우피소(C.auriculatum),극엽우피소(C.bungei) 를 포함하며 적하수오와는 식물학적으로 과속이 다른 품종이다.[4] 백하수오는 기운을 강화시키는 역할을 하기 때문에 심신피로와 신체허약을 좋아지게 해주며, 여성의 갱년기 증상을 완화시켜주고, 남성건강에 좋다고 알려져 있다.
 하수오
하수오하지만, 이런 하수오를 먹고 간이 망가질 수도 있다는 사실을 아는 분은 얼마나 될까?

2010년 대한 간학회 자료에 따르면, 민간요법에 의한 독성 간 손상에 하수오가 2위를 차지할 정도로 하수오에 의한 독성 간손상은 적지 않으며, 드물게 간이식까지 해야 하는 경우도 있다. 이 자료에 있는 하수오는 대부분 적하수오이며, 백하수오는 아직 이런 부작용이 없었다는 보고도 있으나, 백하수오에 의한 독성 간염으로 진단된 환자를 최근에 경험하여 이 글을 쓴다.
2020년 9월 14일, 50대 중반의 남자분이 외래에 방문했다. 환자분은 1주일 전부터 토할 거 같고 미식거리는 증상이 있고, 밥맛이 없으며, 눈이 노래져서 병원에 왔다고 했다. 환자는 아래 사진처럼 피부와 눈의 흰자위가 노랗게 보이는 황달이 관찰되었다.
 황달이 발생한 모습 (참조:Google)
황달이 발생한 모습 (참조:Google)피검사를 우선 시행하였다. 일반적으로 우리가 간수치라고 말하는 AST,ALT 는 40 이내가 정상수치인데 . 이 환자는 AST 가 2179 U/L, ALT 가 2969 U/L 로 무려 500배 이상 상승되어 있었으며, 황달을 알 수 있는 biliruin 수치는 정상이 1.20 이내인데 10.38 mg/dL 로 10 배 이상 상승되어 있었다.
이런 경우는 간에 문제가 있거나 담도(간에서 만들어지는 담즙을 십이지장으로 보내는 관) 에 문제가 있는 경우가 대부분이라서, 정확한 원인 파악을 위해 복부 CT 또는 복부 초음파 등의 검사가 필요하다. 초음파로는 담도의 이상을 확인하지 못하는 경우가 종종 있어서, 복부 CT 검사를 시행하자고 하였다.
 간염으로 인해 담낭벽이 두꺼워져 있다.
간염으로 인해 담낭벽이 두꺼워져 있다.복부 CT 검사 결과는 암이나 담도염의 소견은 없었고, 담낭벽이 두꺼워져 있으나 담낭이 수축되어 있어 담낭염보다는 간염의 소견으로 생각되었고, 황달수치가 더 올라가면 간이식을 하는 경우도 드물게 있어 환자분에게 설명 후 입원하여 치료하기로 하였다.
간염은 진단되었으나, 보다 더 중요한 것은 간염의 원인을 파악하는 것이다. 원인을 모르고 치료만 한다면, 다시 재발할 수 있기 때문이다. 이 환자의 경우 50살이 넘어서 A형 간염의 가능성은 낮았으나, 작년의 경우 우리나라에서 A형 간염이 다른 해에 비해 크게 유행하였고, 50대의 환자도 드물게 발생하였기 때문에, 이 환자도 A형 간염의 가능성을 배제할 수 없었다. 열이 나지 않고, 간수치만 상승한 간염의 경우 간이식을 하는 경우가 아니면 수액 및 약 처방 등의 보존적 치료로 대부분 호전된다. 환자의 전신상태가 나쁘지 않아 우선 간염 검사 결과를 확인하고 원인에 대해 좀 더 고민해보기로 하였다.
다음날 AST 는 1773 U/L, ALT 는 2321 U/L 로 호전되고 있었으나, biliruin 수치는 10.63 mg/dL 로 아직 호전되고 있지 않았다. 다행히 환자의 상태는 나쁘지 않았고, 일상적인 생활이 가능하였다. 이날 간염 검사 결과가 나왔으며, A형과 B형의 항체는 있었고, C형의 항체는 없었다.(A형과 B형의 항원은 없고,항체만 있는 경우 예방접종 등의 효과로 항체가 형성된 것이며, C형은 예방접종이 없어 항체가 없는 것이 정상이다.) A형 간염은 아닌 것이었다. 간염의 원인을 아직 파악하지 못했기에 과거력에 대해서 확인이 필요하였다. 회진시에 물어볼 질문들 (어떤 약을 먹었는 지, 최근에 어떤 곳을 다녀왔는 지 등등) 을 준비해서 물어보았다.
"환자분 최근에 건강보조 식품은 드시지 않으셨어요?"
"네 최근에 하수오를 갈은 가루를 아침에 티 스푼 하나정도 물이랑 같이 마셨어요."
" ..........하수오요?"
" 네, 백하수오를 사서 갈아서 마셨어요. 1달 반 정도 마신 거 같아요."
그렇다. 이 환자의 간염의 원인은 백하수오였던 것이다.
 닥터 하우스의 등장인물
닥터 하우스의 등장인물미국드라마 '닥터하우스'는 희귀한 질병의 원인을 파악하고 진단을 내리는 천재 의사 하우스의 활약상을 중심으로 전개된다. 의대생 및 공중보건의 시절, 내가 잘 알지 못하는 병에 대해 진단 및 치료를 하는 하우스를 보면서 내과의사가 되고 싶었다는 생각을 자주 했었다. 남들이 진단 못하는 병을 진단한 것은 아니지만, 교과서를 보면서 놓친 지점을 하나씩 하나씩 찾아가면서 이 환자의 간염이 발생한 원인이 백하수오인 것을 알았을 때, 나는 정말 기뻤고, 의사로서의 존재가치를 느꼈다.
9월 18일, 드디어 황달수치가 떨어졌다. 13.85 mg/dL 까지 상승했던 bilirubin 수치가 12.91 mg/dL 로 떨어진 것이다. 황달수치가 20이 넘어가면 간이식을 고려해야 하므로, 황달 수치가 떨어지는 것은 매우 중요하다. 환자분에게 황달수치가 좋아졌음을 설명하면서 이전에 드신 백하수오 가루를 더이상 드시지 말 것을 설명드렸다.
환자가 갈아만든 백하수오 가루
환자가 갈아만든 백하수오 가루